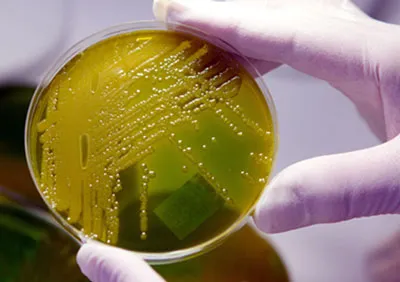
Làm sống lại virus cổ đại

Các nhà khoa học Pháp đã làm sống lại một virus thuộc loại lớn từng sống cách đây khoảng 30.000 năm, nhưng không có hại đối với con người ngày nay.
Virus có tên gọi Pithovirus sibericum đã được tìm thấy ở độ sâu 30m ở bán đảo Chukotka, trên bờ biển Đông Siberia, Nga. Nhiệt độ không khí trung bình hàng năm trong khu vực đóng băng vĩnh cửu này là -13,4°C. Các nhà khoa học đã làm tan băng virus và vi sinh bắt đầu sinh sản trong môi trường sinh vật đơn bào như amip.
Khác với virus cúm, Pithovirus sibericum vô hại đối với con người và động vật, vì chỉ có khả năng lây nhiễm amip Acanthamoeba.
KHÁNH MINH

























